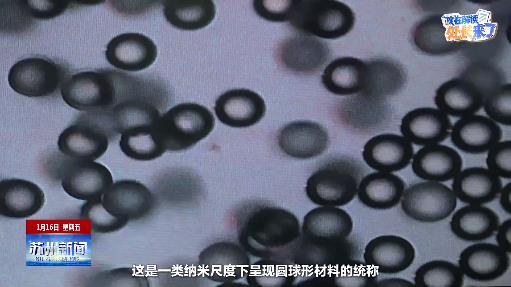

(版權(quán)所有:蘇州廣播電視總臺 未經(jīng)允許不得轉(zhuǎn)載)

最長春節(jié)假期將至 出入境辦證業(yè)務(wù)繁忙

昆山市重點片區(qū)聯(lián)創(chuàng)工作營啟動 玉山歷史文化片區(qū)規(guī)劃發(fā)布

聽障人士呼救120功能上線

吃遍全省風(fēng)味 江蘇十三太保蘇州見“面”

共赴書香之約 蘇州持續(xù)推進(jìn)“閱讀+”建設(shè)

“聽勸”的蘇州文旅 讓旅行更舒心

觀鳥賞湖 太湖邊興起“咖啡車”

代表“帶貨”機(jī)器人

外資持續(xù)加碼 多個項目簽約開工開業(yè)
“扎根強枝” 讓成熟企業(yè)枝繁葉茂
版權(quán)所有:蘇州廣播電視總臺 投訴電話:(0512)62733326? 值班編輯:(0512)62733326? 技術(shù)維護(hù):69150639 電子信箱:admin@vip.2500sz.com
廣告業(yè)務(wù)聯(lián)系: 69150623 69150634 65181411 信息網(wǎng)絡(luò)傳播視聽節(jié)目許可證號 1907177
江蘇省網(wǎng)絡(luò)視聽違規(guī)節(jié)目舉報窗口 蘇ICP備 10008205號-2